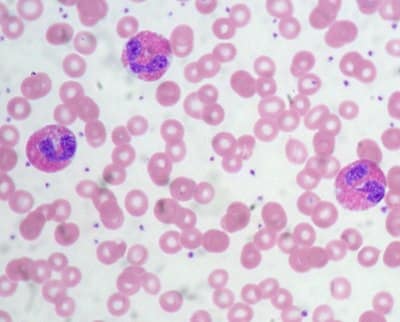
eosinophils 91

Tuesday, March 17
Question of the Day

What is the predominant white blood cell on this peripheral blood smear from a dog, and with what disease process is it often associated?
What is the predominant white blood cell on this peripheral blood smear from a dog, and with what disease process is it often associated?